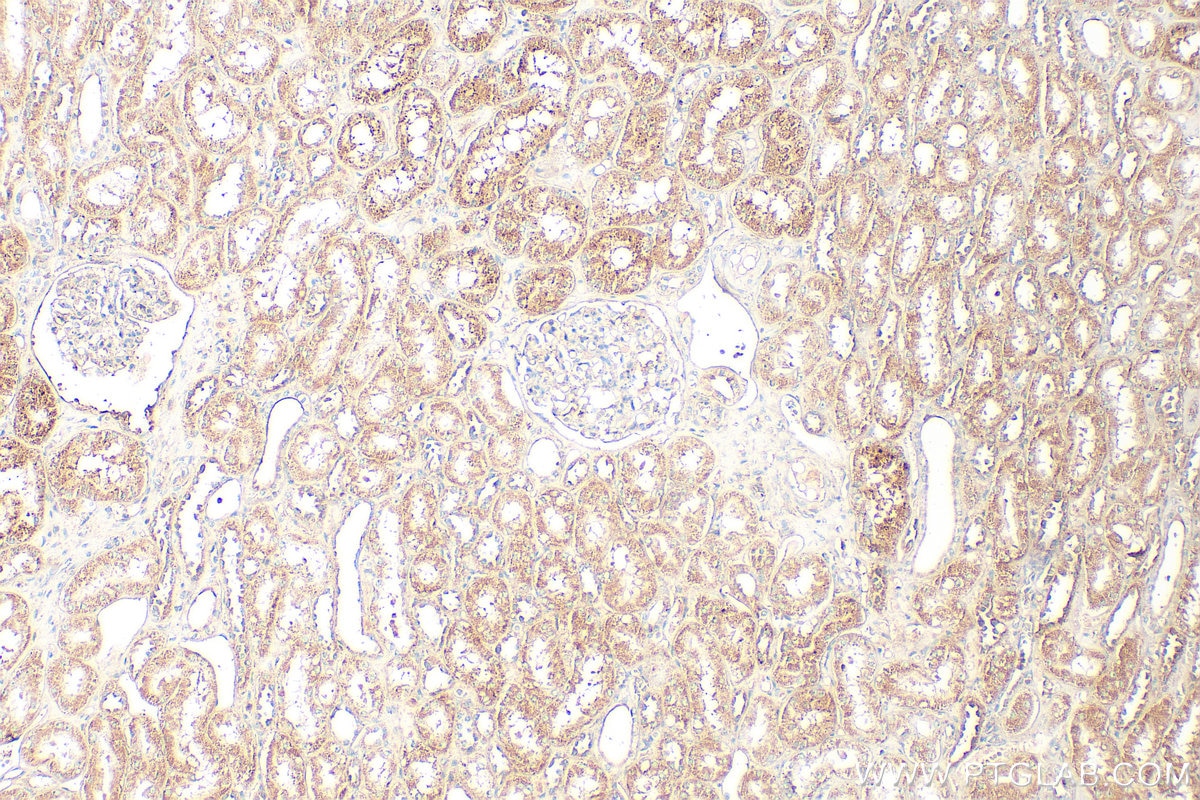
Immunohistochemistry (IHC) staining of human kidney tissue using Spexin Polyclonal antibody (20467-1-AP)
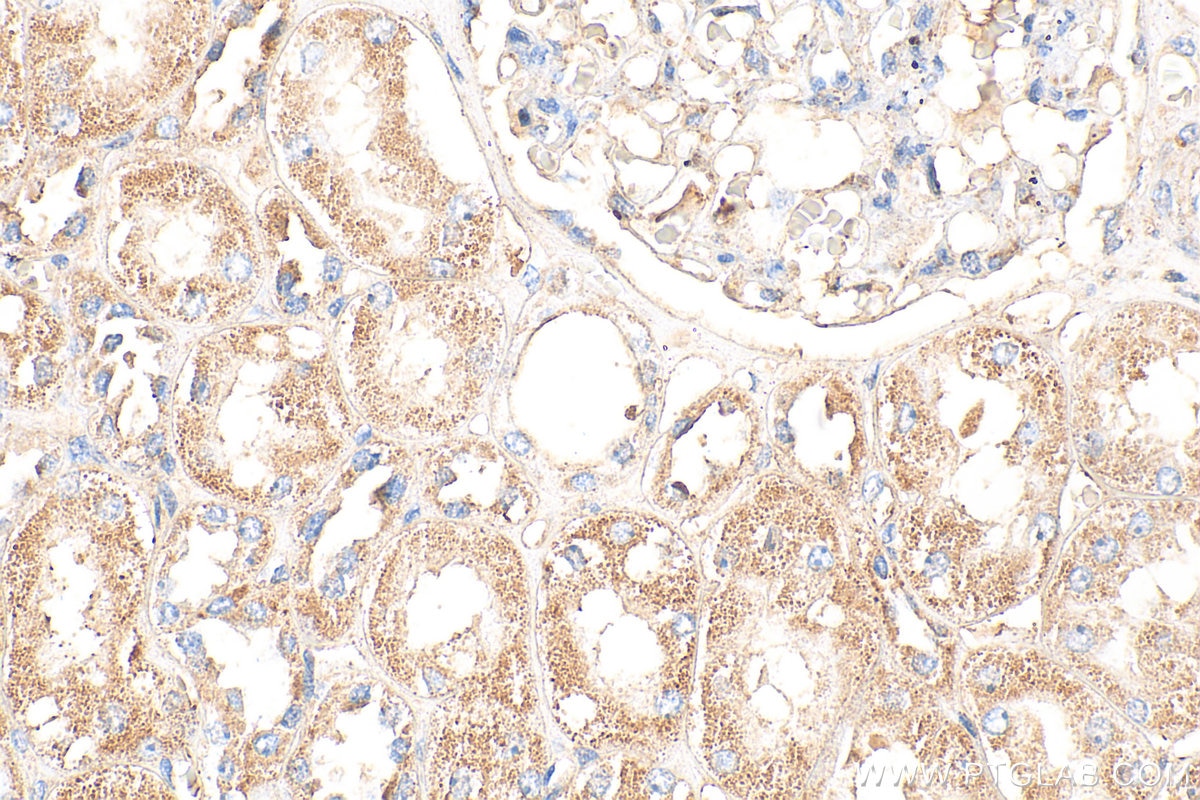
Immunohistochemistry (IHC) staining of human kidney tissue using Spexin Polyclonal antibody (20467-1-AP)

Tested Applications
| Positive IHC detected in | human kidney tissue, mouse heart tissue Note: suggested antigen retrieval with TE buffer pH 9.0; (*) Alternatively, antigen retrieval may be performed with citrate buffer pH 6.0 |
| Positive IF-P detected in | mouse heart tissue, mouse liver tissue |
Recommended dilution
| Application | Dilution |
|---|---|
| Immunohistochemistry (IHC) | IHC : 1:50-1:500 |
| Immunofluorescence (IF)-P | IF-P : 1:50-1:500 |
| It is recommended that this reagent should be titrated in each testing system to obtain optimal results. | |
| Sample-dependent, Check data in validation data gallery. | |
Product Information
20467-1-AP targets Spexin in IHC, IF-P, ELISA applications and shows reactivity with human, mouse samples.
| Tested Reactivity | human, mouse |
| Host / Isotype | Rabbit / IgG |
| Class | Polyclonal |
| Type | Antibody |
| Immunogen |
CatNo: Ag14304 Product name: Recombinant human C12orf39 protein Source: e coli.-derived, PGEX-4T Tag: GST Domain: 1-116 aa of BC004336 Sequence: MKGLRSLAATTLALFLVFVFLGNSSCAPQRLLERRNWTPQAMLYLKGAQGRRFISDQSRRKDLSDRPLPERRSPNPQLLTIPEAATILLASLQKSPEDEEKNFDQTRFLEDSLLNW Predict reactive species |
| Full Name | chromosome 12 open reading frame 39 |
| Calculated Molecular Weight | 116 aa, 13 kDa |
| GenBank Accession Number | BC004336 |
| Gene Symbol | C12orf39 |
| Gene ID (NCBI) | 80763 |
| Conjugate | Unconjugated |
| Form | Liquid |
| Purification Method | Antigen affinity purification |
| UNIPROT ID | Q9BT56 |
| Storage Buffer | PBS with 0.02% sodium azide and 50% glycerol, pH 7.3. |
| Storage Conditions | Store at -20°C. Stable for one year after shipment. Aliquoting is unnecessary for -20oC storage. 20ul sizes contain 0.1% BSA. |
Background Information
Spexin (SPX), also known as neuropeptide Q, is a novel and highly conserved neuroendocrine peptide discovered through bioinformatics. Spexin and its receptors (primarily galanin receptor types 2 and 3) are widely expressed throughout the body, including the central nervous system, gastrointestinal tract, adipose tissue, kidneys, and cardiovascular system. Research indicates that Spexin is a multifunctional regulatory peptide, with its most central role being in energy homeostasis and metabolic regulation. It functions to suppress appetite, reduce body weight, and improve insulin resistance and glucose metabolism, making it a potential biomarker and therapeutic target for metabolic diseases such as obesity and type 2 diabetes. Additionally, Spexin is involved in regulating various physiological and pathological processes, including pain perception, anxiety- and depression-like behaviors, cardiovascular function, and reproductive activities.
Protocols
| Product Specific Protocols | |
|---|---|
| IF protocol for Spexin antibody 20467-1-AP | Download protocol |
| IHC protocol for Spexin antibody 20467-1-AP | Download protocol |
| Standard Protocols | |
|---|---|
| Click here to view our Standard Protocols |